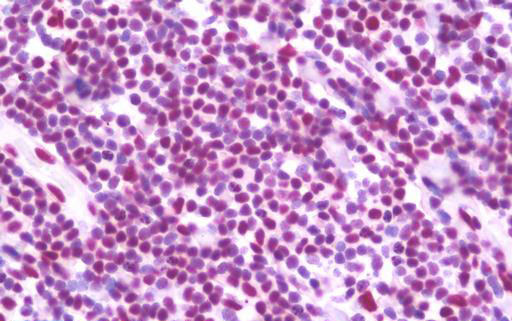

> Antigen, Antibodies, ELISA, Western Blot > Primary Antibody > Polyclonal Antibodies > TRIM28 / KAP1 Antibody (C-Terminus)Brand |
Leading Biology | Catalog Number |
APR03255G |
Product Type |
Polyclonal Antibodies | Field of Research |
|
Product Overview |
We constantly strive to ensure we provide our customers with the best antibodies. As a result of this work we offer this antibody in purified format.
We are in the process of updating our datasheets. If you have any questions regarding this update, please feel free to contact our technical support team.
This product is a high quality TRIM28 / KAP1 Antibody (C-Terminus).
|
||
Molecular Weight |
88550 Da
|
||
Cellular Localization |
Antigen Cellular Localization:
Nucleus Note=Associated with centromeric heterochromatin during cell differentiation through CBX1.
|
||
Host |
Rabbit
|
||
Species Reactivity |
Human, Mouse, Rat
|
||
Target |
At least three isoforms of TRIM28 are known to exist; this antibody will detect all three isoforms.
|
||
Isotype |
IgG
|
||
Symbol |
KAP1, RNF96, TIF1B
|
||
GeneID |
|||
UniProt ID |
|||
Function |
Nuclear corepressor for KRAB domain-containing zinc finger proteins (KRAB-ZFPs). Mediates gene silencing by recruiting CHD3, a subunit of the nucleosome remodeling and deacetylation (NuRD) complex, and SETDB1 (which specifically methylates histone H3 at 'Lys-9' (H3K9me)) to the promoter regions of KRAB target genes. Enhances transcriptional repression by coordinating the increase in H3K9me, the decrease in histone H3 'Lys-9 and 'Lys-14' acetylation (H3K9ac and H3K14ac, respectively) and the disposition of HP1 proteins to silence gene expression. Recruitment of SETDB1 induces heterochromatinization. May play a role as a coactivator for CEBPB and NR3C1 in the transcriptional activation of ORM1. Also corepressor for ERBB4. Inhibits E2F1 activity by stimulating E2F1-HDAC1 complex formation and inhibiting E2F1 acetylation. May serve as a partial backup to prevent E2F1-mediated apoptosis in the absence of RB1. Important regulator of CDKN1A/p21(CIP1). Has E3 SUMO-protein ligase activity toward itself via its PHD-type zinc finger. Also specifically sumoylates IRF7, thereby inhibiting its transactivation activity. Ubiquitinates p53/TP53 leading to its proteosomal degradation; the function is enhanced by MAGEC2 and MAGEA2, and possibly MAGEA3 and MAGEA6. Mediates the nuclear localization of KOX1, ZNF268 and ZNF300 transcription factors.
|
||
Summary |
Nuclear corepressor for KRAB domain-containing zinc finger proteins (KRAB-ZFPs). Mediates gene silencing by recruiting CHD3, a subunit of the nucleosome remodeling and deacetylation (NuRD) complex, and SETDB1 (which specifically methylates histone H3 at 'Lys-9' (H3K9me)) to the promoter regions of KRAB target genes. Enhances transcriptional repression by coordinating the increase in H3K9me, the decrease in histone H3 'Lys-9 and 'Lys-14' acetylation (H3K9ac and H3K14ac, respectively) and the disposition of HP1 proteins to silence gene expression. Recruitment of SETDB1 induces heterochromatinization. May play a role as a coactivator for CEBPB and NR3C1 in the transcriptional activation of ORM1. Also corepressor for ERBB4. Inhibits E2F1 activity by stimulating E2F1-HDAC1 complex formation and inhibiting E2F1 acetylation. May serve as a partial backup to prevent E2F1-mediated apoptosis in the absence of RB1. Important regulator of CDKN1A/p21(CIP1). Has E3 SUMO-protein ligase activity toward itself via its PHD-type zinc finger. Also specifically sumoylates IRF7, thereby inhibiting its transactivation activity. Ubiquitinates p53/TP53 leading to its proteosomal degradation; the function is enhanced by MAGEC2 and MAGEA2, and possibly MAGEA3 and MAGEA6. Mediates the nuclear localization of KOX1, ZNF268 and ZNF300 transcription factors.
|
||
Storage & Stability |
Store at +4°C short term. For long-term storage, aliquot and store at -20°C or below. Stable for 12 months at -20°C. Avoid repeated freeze-thaw cycles.
|
||
Applications |
WB, IHC-P, E
|
||
Dilution |
IHC-P (10 μg/ml), WB (1 - 2 μg/ml),
|
||
Images |
Anti-TRIM28 / KAP-1 antibody IHC staining of human tonsil. 
Western blot analysis of TRIM28 in human testis tissue lysate with TRIM28 antibody at 1 ug/ml. |
||
Specification |
|||
Quantity |
|
||
| Select | Brand | Catalog No. | Product Name | Pack Size | Type | Field of Research | Specification | Quantity | Price(USD) | |
| 1 | Leading Biology | APR03440G | ITGA11 Antibody (N-term) | 100 μl | Polyclonal Antibodies |
|
$495.00 | Add Ask | ||
| 2 | Leading Biology | APR04537G | CMIP Antibody (C-term) | 100 μl | Polyclonal Antibodies |
|
$495.00 | Add Ask | ||
| 3 | Leading Biology | APR12422G | Human H4 Histamine Receptor (extracellular) Antibody | 50 μl | Polyclonal Antibodies |
|
$695.00 | Add Ask | ||
| 4 | Leading Biology | APR03844G | UBE2W Antibody (C-term) | 100 μl | Polyclonal Antibodies |
|
$495.00 | Add Ask | ||
| 5 | Leading Biology | APR04349G | HECTD2 Antibody (N-term) | 100 μl | Polyclonal Antibodies |
|
$495.00 | Add Ask | ||
| 6 | Leading Biology | APR03502G | IGHG1 Antibody (Center) | 100 μl | Polyclonal Antibodies |
|
$495.00 | Add Ask |
 Leading Biology Inc.
2600 Hilltop DR, Building G, B Suite C138
Richmond, CA, 94806
Tel: 1-661-524(LBI)-0262
Email: info@leadingbiology.com
Leading Biology Inc.
2600 Hilltop DR, Building G, B Suite C138
Richmond, CA, 94806
Tel: 1-661-524(LBI)-0262
Email: info@leadingbiology.com
Complete this form and click send to ask us a question, request a quote or simply say hello.

You have 0 item in your cart

You have 0 item in your inquiry list
